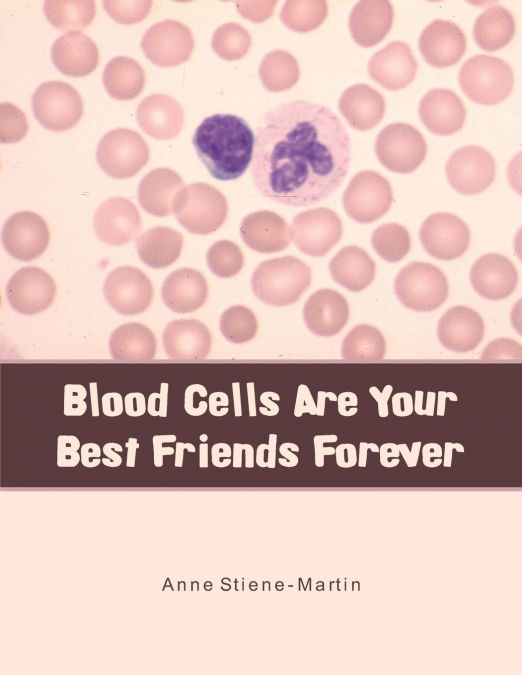

Esta web utiliza cookies propias y de terceros que nos permiten optimizar tu experiencia en el sitio web, evaluar su rendimiento, generar estadísticas de uso y mejorar y añadir nuevas funcionalidades. Mediante el análisis de tus hábitos de navegación podemos mostrar contenidos más relevantes y medir las interacciones con la web.
Puede obtener más información aqui.
Uma cookie é um ficheiro que se descarrega no seu computador ao aceder a determinadas páginas web.As cookies permitem a uma página web, entre outras coisas, armazenar e recuperar informação sobre os hábitos de navegação de um usuário ou do seu equipamento, gerir o acesso de usuários a zonas restritas da web, etc.Que tipo de cookies utiliza esta página web:
Este tipo de cookies permiten al usuario la navegación a través de una página web, plataforma o aplicación y la utilización de las diferentes opciones o servicios que en ella existan como, por ejemplo, controlar el tráfico y la comunicación de datos, identificar la sesión, acceder a partes de acceso restringido, seleccionar el idioma, o compartir contenidos a través de redes sociales.
| Nombre | Descripcion | Duración | Habilitado |
|---|---|---|---|
| ID de tu sesión. Te identifica en este navegador y nos permite gestionar tus cookies o almacenar tu cesta de la compra. | 8760 horas | ||
| Indica qué cookies has aceptado. | 8760 horas | ||
| Una cookie PHPSESSID es una cookie de sesión que se utiliza para identificar la sesión de un usuario en un sitio web. | 8760 horas |
Son aquéllas que posibilitan el seguimiento y análisis del comportamiento de los usuarios en nuestra página. La información recogida se utiliza para la medición de la actividad de los usuarios en la web y la elaboración de perfiles de navegación de los usuarios, con la finalidad de mejorar la web, así como los productos y servicios ofertados.
| Nombre | Descripcion | Duración | Habilitado |
|---|---|---|---|
| Es un servicio de analítica web que utiliza cookies de análisis. | 8760 horas |
Estas cookies pueden ser establecidas a través de nuestro sitio por nuestros socios publicitarios. Pueden ser utilizadas por esas empresas para crear un perfil de sus intereses y mostrarle anuncios relevantes en otros sitios. No almacenan directamente información personal, sino que se basan en la identificación única de su navegador y dispositivo de Internet. Si no permite utilizar estas cookies, verá menos publicidad dirigida.
| Nombre | Descripcion | Duración | Habilitado |
|---|
O que são os cookies?
Um cookie é um arquivo descarregado no seu computador para aceder certos sites. Os cookies permitem que um site, entre outras coisas, possa armazenar e recuperar informações sobre os hábitos de navegação de um/a usuário/a ou do seu computador, gerenciar o acesso do/a usuário/a às áreas restritas do site etc.
Que tipo de cookies utiliza este site?
Cookies de análise
São aqueles que permitem a monitorização e análise do comportamento do/a usuário/a no nosso site. A informação recolhida é usada para medir a atividade dos/as usuários/as no site e para criar perfis de navegação do/a usuário/a, a fim de melhorar o site e os produtos e serviços oferecidos.
Cookies técnicos
Permitem ao/à usuário/a navegar através dum site, plataforma ou aplicação e o uso de diferentes opções ou serviços que existem, como por exemplo o controlo do tráfego e comunicação de dados, identificar a sessão, aceder a áreas de acesso restrito, ou compartilhar conteúdos através de redes sociais.
Cookies de personalização
São aqueles que permitem adaptar a navegação no site com as suas preferências, como o idioma, navegador utilizado etc.
| Nome | Própria / Terceiros | Duração | Descrição | Proprietário |
| gat | Terceiros | 1 minuto | É usado para limitar a porcentagem de solicitações. | Google Analytics |
| _ga | Terceiros | 2 anos | É usado para distinguir os usuários. | Google Analytics |
| _gid | Terceiros | 24 horas | É usado para distinguir os usuários. | Google Analytics |
| PHPSESSID | Própria | Sesion | Cookie de sessão, desaparece quando a web é fechada. | Arnoia |
| COOKIE_CONSENT | Própria | 1 mês | Cookie de personalização. | Arnoia |
| SESS_ID | Própria | 10 dias | Cookie de sessão. | Arnoia |

This book is aimed at young people (ages eight to twelve). It describes each of the blood cells or formed elements in blood, using cartoons as illustrations. Each cell is described as to its appearance, its function or job, how it does its job, where it came from, what can go wrong, and what the reader can do to help.
